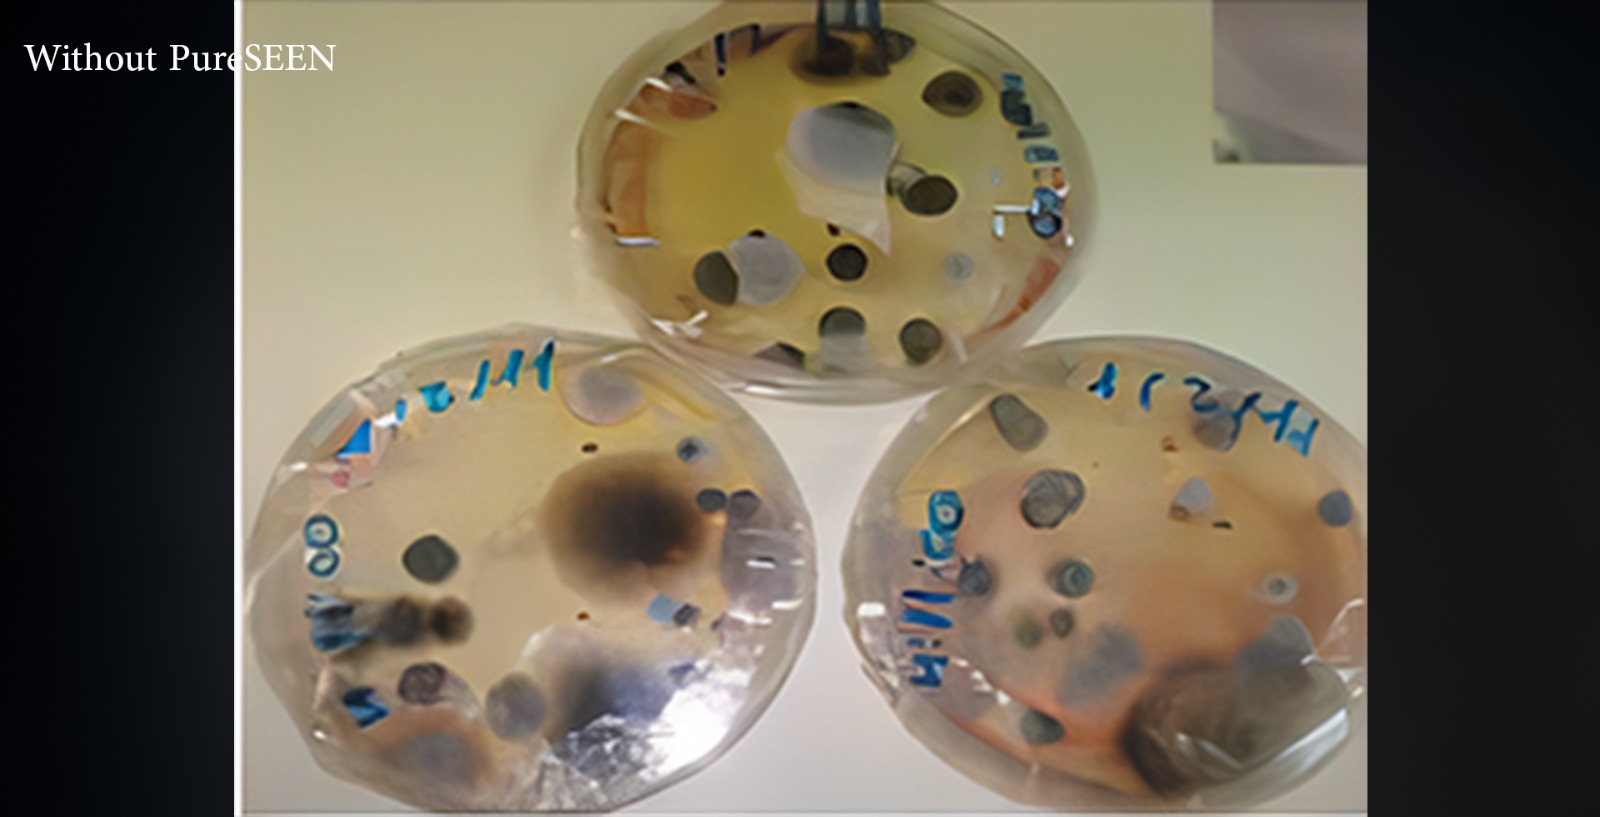

Solutions that impact positively and economically on current and future worldwide concerns such as Health, Energy, and Environment





Technology & Mechanism
Photocatalysis sends out purifying agents to destroy, dangerous bacteria, viruses, allergy-causing mold, and VOCs in the air.
Under the action of UV light (UV-A /UV-C), the catalyst (titanium dioxide TiO2) creates electric charges on its surface (e-electrons and h+ holes), which react with the dioxygen and water naturally present in the air to form radicals.
Our Technology is the only one that combines up to five nature-based technologies working together to treat indoor air like nature cleans outdoor air.
Using two types of ionization to reduce particles, UV and a catalyst to create oxygen and hydrogen-based friendly oxidizers to Eliminate microbial contaminants, and low-level ozone to reduce odors unlike other products in the market, these air purification products represent active technologies that bring the solution directly to the problem, rather than Requiring air to go physically through the unit (passive technology).
Our Product
Our double lionization technology removes fine dust and pollen particles from the air (250 times quicker than gravity). Perfect for indoor pollution control, and odor reduction. Contamination prevention, etc.

Benefits Of Using
PureSEEN
Our Industries
HOSPITALITIES & PUBLIC PLACES
24/7 Air & surface disinfection and odor control
CRECHES AND SCHOOLS
24/7 Air and surface disinfection
FRUIT AND VEGETABLES
Prolonged storage life
Energy efficient transportation
FOOD AND BEVERAGE
Infection control (Air & Surfaces)
Temperature & Humidity Control
HEALTH CARE
HEALTH CARE
BANKS
27/7 Air & Surface disinfection
Prolong life of used notes

All Microbes Target
SARS-CoV-2 (virus) | Staphylococcus Aureus (Gram+ bacteria) | Aspergillus Niger (endospore; Toxic Black Mold surrogate) |
H1N1 (Swine Flu; Influenza A virus) | H5N8 (Bird Flu; Influenza A virus) | Methicillin-Resistant Staphylococcus Aureus (MRSA; Gram+ bacteria) |
Bacillus Globigii (bacterial endospore; Anthrax surrogate) | MS2 (RNA bacteriophage virus) | Staphylococcus Epidermis (Gram+ bacteria) |
Phi-X174 (DNA bacteriophage virus) | Erwinia Herbicola (Gram- bacteria) | Listeria Monocytogenes (Gram+ bacteria) |
Murine Norovirus (virus) | Escherichia Coli (E. Coli; Gram- bacteria) | Candida Auris (fungus) |
Botrytis Cinerea (fungus) | Sclerotinia Sclerotiorum (fungus) | Legionella Pneumophila (Gram- bacteria) |
Aspergillus Versicolor (fungus) | Clostridioides Difficile (C. Diff; endospore) | Salmonella Enterica (Gram- bacteria) |
MPX-HUG-2 (Monkeypox; virus) |